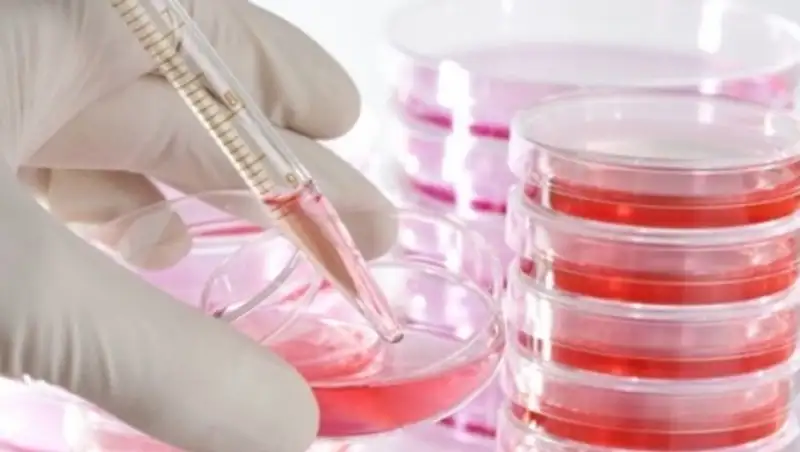

Ежегодно около 300 казахстанцев нуждаются в пересадке костного мозга
Zakon.kz
Zakon.kz
На сегодняшний день в Казахстане катастрофически не хватает доноров костного мозга.
В Казахстане всего около 5 тысяч доноров костного мозга – эта цифра очень мала. Каждый год порядка 300 человек в стране нуждаются в пересадке костного мозга. Об этом в ходе пресс-конференции сообщил руководитель национального регистра доноров костного мозга и развития трансплантации Научно-производственного центра трансфузиологии Дулат Имашпаев, передает корреспондент Kazpravda.kz.
"Ежегодно около 300 человек в Казахстане нуждается в трансплантации стволовых клеток, половина из них дети и подростки. В прошлом году проведено 57 трансплантаций от родственного донора и одна не родственная трансплантация от донора из России", – отметил доктор.
Согласно статистике, у 63% детей с хроническим миелолейкозом и 39% с хроническим миеломоноцитарным лейкозом прошедших операцию наблюдается пятилетняя выживаемость. В то же время при лечении химиотерапией выживают всего лишь 18%.
В целях улучшения работы по поиску доноров в Казахстане в 2011 году была создана база данных, добавил Имашпаев.
"Регистр доноров костного мозга применяется для трансплантации стволовых клеток. На сегодняшний день это является наиболее ярким примером успешного и широкого применения клеточных технологий. Цель создания регистра доноров стволовых клеток – это спасение жизни наших соотечественников, страдающих онкогемотологическими заболеваниями и другими онкозаболеваниями", – сообщил Дулат Имашпаев.
Вместе с тем, он посетовал, что в стране незначительное число желающих предоставить свой биоматериал для спасения жизни онкобольных. "У нас всего лишь около 5 тысяч человек, которые дали согласие на безвозмездное дарение своих клеток. Для этого мы заключаем договоры с международными организациями и пытаемся максимально улучшить ситуацию в этой области. Надеюсь, что в ближайшие 5 лет мы сможем охватить весь Казахстан и у нас не будут страдать люди", – проинформировал Дулат Имашпаев.
Доктор также добавил, что донором стволовых клеток в Казахстане может стать любой человек в возрасте от 18 до 55 лет, при условии что он не является носителем ВИЧ-инфекции, не болел сифилисом, гепатитом B,C и туберкулезом.
Автор: Шынар Оспанова
Фото Kazpravda.kz
Поделитесь новостью
Читайте также
Если вы видите данное сообщение, значит возникли проблемы с работой системы комментариев. Возможно у вас отключен JavaScript













